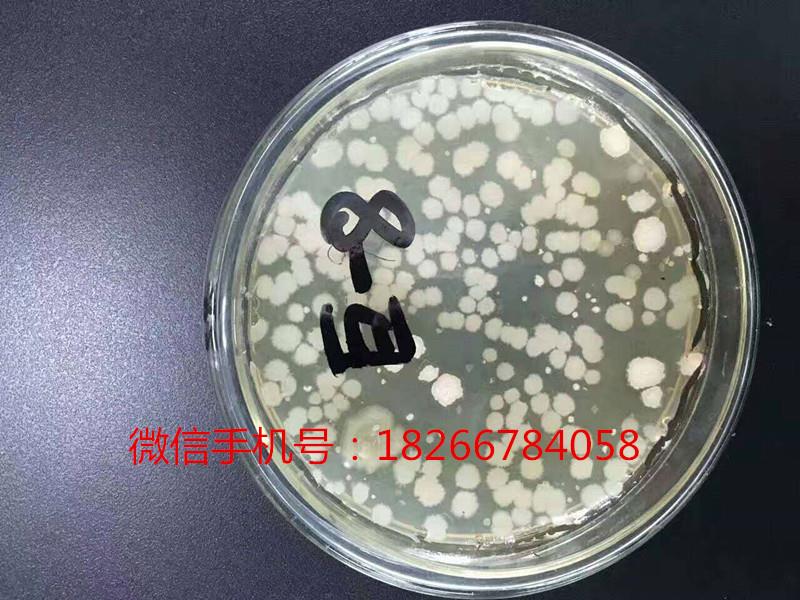
五代酵母补硒产品（酵母补代产品硒含量多少）-硒宝网

五代酵母补硒产品(酵母补代产品硒含量多少)
专利名称:饲料用硒酵母及其制备方法
技术领域:
本发明涉及一种饲料用硒酵母及其制备方法,特别是关于一种选用优质的酵母菌 种和无机硒源,采用液、固态联合发酵技术制备饲料用硒酵母的方法,以及按照该方法所制 备得到的饲料用硒酵母。
背景技术:
微量元素硒具有参与谷胱肝肽过氧化酶使人和动物机体免受自由基和辐射的破 坏、维持细胞呼吸、刺激免疫反应、?;じ卧?、抑制癌细胞等作用。在传统的饲料和饲料添加 剂的生产中,已广泛使用无机硒——亚硒酸钠作为微量元素硒的补充剂。但亚硒酸钠的毒 性大,使用或管理不当,会造成严重不良后果,因而欧美、日本等发达国家在动物饲料中不 再使用此类无机硒源。研究表明,有机硒,特别是硒酵母的生物利用率高,能有效地提高动物体内的血硒 水平,可作为饲料添加剂用于反刍类动物,是一种很有市场前景的硒补充剂。硒酵母是一种 生物制剂,啤酒酵母、产朊假丝酵母具有生长繁殖快、发酵周期短、对微量元素吸收率高等 特点,是将无机硒转换为有机硒的理想载体,无机硒进入酵母细胞后,同氨基酸或蛋白质结 合形成类似天然食品中的有机硒(硒蛋氨酸、硒胱氨酸),其中有机硒含量占总硒的90%以 上,并可忽略硒酵母中无机硒含量,且其活性与吸收率是无机硒的10 20倍。现有技术中 的硒酵母中的硒含量一般在500mg/kg以下。目前我国硒酵母的制备还处于实验室研究阶段,未实现实际生产,相关研究还缺 乏对富硒发酵的最优条件的探索,不具备规模生产的指导意义。
发明内容
本发明的一个目的在于提供一种制备饲料用硒酵母的方法,采用简便易行的发酵 工艺,以制备一种高硒含量的硒酵母,且该方法易于规?;凳?。本发明的另一目的在于提供一种按照所述的方法制备得到的硒酵母,其中含有较 高含量的有机硒以及活性酵母,可作为饲料或饲料添加剂。—方面,本发明提供了一种微生物发酵制备饲料用硒酵母的方法,其中主要是选 用优质的酵母菌种,先接种到添加亚硒酸钠的种子罐液体培养基中进行扩大培养,然后再 接种到固态浅盘中发酵,干燥后得到本发明的饲料用硒酵母。根据本发明的具体实施方案,本发明提供的微生物发酵制备饲料用硒酵母的方法 包括将啤酒酵母按每环40 80ml的比例接种到麦芽汁增菌培养基(或称一级增菌培 养基)中,观 32°C振荡22 72小时优选22 32小时进行一级增菌培养;将二级种子培养基(或称二级增菌培养基)加热至55°C 65°C,加入α-淀粉 酶(α -淀粉酶的加入量根据培养基中的淀粉含量而定,每克淀粉加入6 IOU酶活的淀粉 酶)保温水解2 3小时,然后加入糖化酶(糖化酶的加入量也是根据培养基中的淀粉含量而定,每克淀粉加入100 180U酶活的糖化酶),维持55°C 65°C糖化2 3小时,之后 升温至100°C 125°C灭菌15 30分钟,再加入硒酸盐或亚硒酸盐使该培养基中硒浓度达 到20 25μ g/ml ;并将该培养液冷却至35°C以下,按8% 12%的比例接入上述经一级增 菌培养后的啤酒酵母菌液,在温度 32°C振荡培养22 48小时进行二级增菌培养;将上述经二级增菌培养的菌液与饲料发酵底物和水按照1 2 10 20 5 10的重量比混勻,在30 45°C条件下发酵36 78小时,将发酵结束后的物料烘干、粉碎, 即得饲料用硒酵母成品。
根据本发明的优选具体实施方案,本发明的方法中,所述麦芽汁增菌培养基是按 以下方法制成的麦芽汁加6 10倍体积的蒸馏水,糖度调节至4 10波林(Balling),pH调至 5. 5 6. 5,在100 125°C温度下灭菌15 30分钟。根据本发明的优选具体实施方案,本发明的方法中,所述二级种子培养基是由玉 米粉、麸皮、营养盐加水混合制成的,具体是按以下方法制成的玉米粉15 20重量份、麸皮3 8重量份、营养盐1 2重量份加水70 81重 量份,混合均勻,PH调至3. 6 4. 8制成。根据本发明的优选具体实施方案,本发明的方法中,所述饲料发酵底物(固体发 酵底物)是由玉米粉、棉粕、豆粕、油菜粕、麸皮、营养盐、添加硒酸盐或亚硒酸盐加水混勻 后制成的,具体是按以下方法制成的玉米粉50 70重量份、棉粕8 12重量份、豆粕8 12重量份、油菜粕4 8 重量份、麸皮5 10重量份、营养盐1 2重量份、硒酸盐或亚硒酸盐0. 5 1重量份混合 均勻,制成饲料发酵底物。根据本发明的优选具体实施方案,本发明的方法中,所述营养盐是由磷酸二氢钾、 硫酸铵、葡萄糖按照2 4 8 12 1 3的重量比混合均勻制成。
根据本发明的优选具体实施方案,本发明的方法中,所述经二级增菌培养的菌液 与饲料发酵底物和水混合步骤中,所述的水的PH值为5. 0 7. 0,所述饲料发酵底物的粒度 为3 8mm,混合完毕后将混合物堆成高为10 40cm的梯形堆,在30 45°C条件下发酵 36 78小时。根据本发明的优选具体实施方案,本发明的方法中,所述烘干步骤中,控制烘干温 度不高于60°C,优选不高于45°C。根据本发明的优选具体实施方案,本发明的方法中,所述烘干后的物料的粉碎粒 度为至少75%通过80目筛、至少95%通过40目筛、100%通过20目筛。在本发明的一优选的具体实施方案中,本发明的微生物发酵制备饲料用硒酵母的 方法是按照以下方法进行的将试管斜面上的啤酒酵母按每环40 80ml的比例接种于装有麦芽汁增菌培养 基(由麦芽汁加6 10倍体积的蒸馏水,糖度调节至4 10波林,pH调至5. 5 6. 5,在 100 125°C温度下灭菌15 30分钟制成)的三角瓶中,塞上瓶塞,并用封口膜包好,在 28 32°C、100 180转/分钟条件下振荡22 72小时进行一级增菌培养;将二级种子培养基(由玉米粉15 20重量份、麸皮3 8重量份、营养盐1 2 重量份加水70 81重量份混合均勻,pH调至3. 6 4. 8制成)加热至55°C 65°C,加入适量α -淀粉酶(根据培养基中每克淀粉加入6 IOU酶活的淀粉酶)保温水解2 3小 时,然后加入适量糖化酶(根据培养基中每克淀粉加入100 180U优选120 160U酶活 的糖化酶),维持 65°C糖化2 3小时,之后升温至100°C 125°C灭菌15 30分 钟,再降温到50°C以下,将亚硒酸钠溶液按一定比例添加到该培养基中,使该培养基中硒浓 度达到20 25 μ g/ml,培养液继续冷却至35°C以下,将上述经过一级增菌培养的啤酒酵母 菌液按8% 12%的质量比接种,在温度为 32°C、100 180转/分钟条件下搅拌培 养22 48小时进行二级增菌培养;将上述经过二级增菌培养的菌液与水(事先用无机酸或有机酸例如HC1、柠檬酸 等调节pH至5. 0 7. 0)、饲料发酵底物(由玉米粉50 70重量份、棉粕8 12重量份、 豆粕8 12重量份、油菜粕4 8重量份、麸皮5 10重量份、营养盐1 2重量份、硒酸 盐或亚硒酸盐0. 5 1重量份混合均勻制成,粒度为3 8mm)以1 2 5 10 10 20的重量比均勻混合,混合完毕后将其堆成高为10 40cm优选10 30cm的梯形堆,同时 以地暖在30 45°C条件下发酵36 78小时,发酵结束后用烘干机烘干,为减少烘干温度 对饲料中活性组分的破坏,所述烘干步骤中,优选控制温度不高于60°C,更优选40°C以下, 之后将烘干后的物料粉碎,优选的粉碎粒度为至少75%通过80目筛、至少95%通过40目 筛、100%通过20目筛,粉碎后分装即成品。
本发明还提供了按照上述方法制备得到的饲料用硒酵母。该饲料用硒酵母中,有 机硒含量600 1000微克/g,酵母活菌数高达18亿/g以上,粗蛋白含量高达32%以上。 本发明的的饲料用硒酵母,可以作为饲料或饲料添加剂,用于饲喂动物特别是反刍动物以 补充硒元素。相关实验表明,利用本发明的硒酵母饲喂动物可以增加反刍动物乳中硒的含 量;减少乳体中SCC数;提高犊牛成活率;减少每次妊娠的配种次数;减少胎衣不下、子宫 炎等疾病的发生率;提高饲料转化率,减少死亡率,提高机体抗病力和免疫力,加快机体对 疫苗的反应。综上所述,本发明选用性能优良的酵母菌种,并采用液、固结合的发酵工艺,经过 对接种后的培养基进行深度发酵后,可获得大量的富硒酵母产品,从而提供了一种易于规 ?;奈湍傅闹票阜椒鞍凑崭梅椒ㄋ票傅玫降奈湍浮1痉⒚鞯奈湍讣捌渲?备方法具有以优点1、本发明的方法采用液、固结合的发酵工艺,经过对接种后的培养基进行深度发 酵后,获得大量的富硒酵母产品,采用此技术可有效提高硒的转化率避免单质硒的生成。同 时固态发酵生产硒酵母相对于纯液态发酵,技术较简单成本较低,设备投入少,可以进行规 ?;?。
2、本发明对发酵设备及条件没有特殊要求,一般发酵厂的设备和条件均可生产, 生产投资较少,方法简单,成本低廉,实用性强,操作简便,易于普遍推广。3、本发明的硒酵母产品中有机硒含量较高,质量好,其有机硒含量高达每克发酵 物含500 1000微克,同时本发明产品中含酵母活菌数20亿/g,粗蛋白含量35%。该硒 酵母产品安全无毒,投资少、见效快、效益高。
图1为本发明的微生物发酵制备硒酵母的流程示意图。
具体实施例方式以下通过具体实施例详细说明本发明的技术及特点,但这些实施例并非用以限定 本发明的?;し段АJ凳├镁直痉⒚饕韵率凳├兴闷【平湍?(Saccharemycescerevisiae)菌种购买于中国微生物菌种保藏管理委员会普通微生物中 心。保藏号为CGMCC AS2. 2。实施例1按照以下方法制备本实施例的硒酵母,可同时参见图1所示的流程一级增菌培养将试管斜面上的啤酒酵母挑取五环接种在装有300ml麦芽汁增菌 培养基(所述麦芽汁增菌培养基由麦芽汁130g加IOOOml蒸馏水,糖度调节至8波林,pH调 至6.0,在121 °C温度下灭菌20分钟制成,量取300ml)的三角瓶中(三角瓶容量500ml),塞 上瓶塞,并用封口膜包好,在30°C、120转/分钟条件下振荡M小时进行一级增菌培养;二级增菌培养将50kg 二级种子培养基(由玉米粉8重量份、麸皮2重量份、营养 盐(由磷酸二氢钾、硫酸铵、葡萄糖按照1. 5 5 1混合均勻制成)0. 75重量份加水39. 25 重量份混合均勻,PH调至4. 0,121°C灭菌30分钟制成)加热至60°C,根据培养基中每克淀 粉加入8U酶活的α -淀粉酶保温水解3小时,然后根据培养基中每克淀粉加入140U酶活 的糖化酶,维持60°C糖化2小时,之后升温至120°C灭菌30分钟,再降温到50°C以下,将亚 硒酸钠溶液(硒含量43. 806mg/ml)按一定比例添加到该培养基中,使该培养基中硒浓度达 到25 μ g/ml,培养液继续冷却至35°C以下,将上述经过一级增菌培养的啤酒酵母菌液5kg 接种到该二级培养基中,在温度为30°C、130转/分钟条件下搅拌培养M小时进行二级增 菌培养;固态发酵将上述经过二级增菌培养的菌液50kg与水(事先用无机酸或有机酸 例如HC1、柠檬酸等调节pH至6. 0) 250kg、饲料发酵底物(玉米粉32^g、棉粕50kg、豆粕 50kg、油菜粕30kg、麸皮35kg、营养盐7. 5kg (由磷酸二氢钾1. ^g、硫酸铵^g、葡萄糖Ikg 混合均勻制成)、亚硒酸盐2. 5kg混合均勻制成,粒度为3 8mm) 500kg以1 2 5 10 10 20的重量比均勻混合,混合完毕后将其堆成高为20cm的梯形堆,同时以地暖在 30°C条件下发酵72小时,发酵结束后用烘干机烘干,为减少烘干温度对饲料中活性组分的 破坏,所述烘干步骤中控制温度45°C左右,之后将烘干后的物料粉碎,优选的粉碎粒度为至 少75%通过80目筛、至少95%通过40目筛、100%通过20目筛,粉碎后分装即成品。
本发明还提供了按照上述方法制备得到的饲料用硒酵母。该饲料用硒酵母中,有 机硒含量777 μ g/g,酵母活菌数高达20亿/g,粗蛋白含量高达35 %。实施例2按照以下方法制备本实施例的硒酵母一级增菌培养将试管斜面上的啤酒酵母按每环约60ml的比例接种于装有麦芽 汁增菌培养基(由麦芽汁加7. 5倍体积的蒸馏水,糖度调节至6波林,pH调至6. 5,在120°C 温度下灭菌25分钟制成)的三角瓶中,塞上瓶塞,并用封口膜包好,在30°C、120转/分钟 条件下振荡M小时进行一级增菌培养;二级增菌培养将IOOkg 二级种子培养基(由玉米粉18重量份、麸皮4重量份、营养盐(由磷酸二氢钾、硫酸铵、葡萄糖按照1.5 5 1混合均勻制成)1. 5重量份加水 76. 5重量份混合均勻,pH调至4. 5,121°C灭菌30分钟制成)加热至60°C,根据培养基中每 克淀粉加入8U酶活的α -淀粉酶保温水解2. 5小时,然后根据培养基中每克淀粉加入140U 酶活的糖化酶,维持60°C糖化2. 5小时,之后升温至121°C灭菌20分钟,再降温,加入亚硒 酸钠溶液(硒含量43. 806mg/ml),使该培养基中硒浓度达到20 μ g/ml,培养液继续冷却至 35°C以下,将上述经过一级增菌培养的啤酒酵母菌液IOkg接种到该二级培养基中,在温度 为30°C、150转/分钟条件下搅拌培养M小时进行二级增菌培养;固态发酵将上述经过二级增菌培养的菌液IOOkg与水600kg (事先用无机酸或有 机酸例如HC1、柠檬酸等调节pH至6.幻、饲料发酵底物1000kg(由玉米粉60重量份、棉粕 10重量份、豆粕10重量份、油菜粕6重量份、麸皮7重量份、营养盐1. 5重量份、亚硒酸盐 0. 75重量份混合均勻制成,121°C灭菌30分钟,粒度为3 8mm)均勻混合,混合完毕后将其 堆成高为30cm的梯形堆,同时以地暖在45°C条件下发酵48小时,发酵结束后用烘干机烘 干,烘干温度50°C,之后将烘干后的物料粉碎,优选的粉碎粒度为至少75%通过80目筛、至 少95%通过40目筛、100%通过20目筛,粉碎后分装即得本实施例的饲料用硒酵母成品。
本实施例制得的饲料用硒酵母。该饲料用硒酵母中,有机硒含量682微克/g,酵母 活菌数18. 5亿/g以上,粗蛋白含量高达33. 8%。实施例3按照以下方法制备本实施例的硒酵母一级增菌培养将试管斜面上的啤酒酵母按每环50ml的比例接种于装有麦芽汁 增菌培养基(由麦芽汁加8倍体积的蒸馏水,糖度调节至10波林,pH调至6. 0,在121°C温 度下灭菌20分钟制成)的三角瓶中,塞上瓶塞,并用封口膜包好,在30°C、150转/分钟条 件下振荡观小时进行一级增菌培养;二级增菌培养将50kg二级种子培养基(由玉米粉15重量份、麸皮5重量份、营养 盐(由磷酸二氢钾、硫酸铵、葡萄糖按照1.5 5 1混合均勻制成)1. 5重量份加水78. 5 重量份混合均勻,PH调至4. 0,121°C灭菌20分钟制成)加热至55°C,根据培养基中每克淀 粉加入8U酶活的α -淀粉酶保温水解2. 5小时,然后根据培养基中每克淀粉加入140U酶活 的糖化酶,维持55°C糖化约2小时,之后升温至121°C灭菌20分钟,再降温,加入亚硒酸钠 溶液(硒含量43. 806mg/ml),使该培养基中硒浓度达到25 μ g/ml,培养液继续冷却至35°C 以下,将上述经过一级增菌培养的啤酒酵母菌液约5kg接种到该二级培养基中,在温度为 30°C、150转/分钟条件下搅拌培养M小时进行二级增菌培养;固态发酵将上述经过二级增菌培养的菌液约55kg与水330kg (事先用无机酸或 有机酸例如HCl、柠檬酸等调节pH至6. 0)、饲料发酵底物820kg (由玉米粉60重量份、棉粕 10重量份、豆粕8重量份、油菜粕6重量份、麸皮8重量份、营养盐1. 2重量份、亚硒酸盐0. 8 重量份混合均勻制成,粒度为3 8mm,121°C灭菌30分钟)均勻混合,混合完毕后将其堆 成高为20cm的梯形堆,同时以地暖在40°C条件下发酵72小时,发酵结束后用烘干机烘干, 烘干温度40°C,之后将烘干后的物料粉碎,优选的粉碎粒度为至少75%通过80目筛、至少 95%通过40目筛、100%通过20目筛,粉碎后分装即得本实施例的饲料用硒酵母成品。
本实施例制得的饲料用硒酵母。该饲料用硒酵母中,有机硒含量880微克/g,酵母 活菌数高达约23. 2亿/g以上,粗蛋白含量高达37. 6%。
权利要求
1.一种饲料用硒酵母的制备方法,该方法包括将啤酒酵母按每环40 80ml的比例接种到麦芽汁增菌培养基中,28 32°C振荡22 72小时进行一级增菌培养;将二级种子培养基加热至 65°C,加入α -淀粉酶保温水解2 3小时,然后加 入糖化酶,维持55°C 65°C糖化2 3小时,之后升温至100°C 125°C灭菌15 30分 钟,再加入硒酸盐或亚硒酸盐使该培养基中硒浓度达到20 25μ g/ml ;并将该培养液冷 却至35°C以下,按8% 12%的比例接入上述经一级增菌培养后的啤酒酵母菌液,在温度 32°C振荡培养22 48小时进行二级增菌培养;将上述经二级增菌培养的菌液与饲料发酵底物和水按照1 2 10 20 5 10 的重量比混勻,在30 45°C条件下发酵36 78小时,将发酵结束后的物料烘干、粉碎,即 得饲料用硒酵母成品。
2.根据权利要求1所述的方法,其中,所述麦芽汁增菌培养基是按以下方法制成的 麦芽汁加6 10倍体积的蒸馏水,糖度调节至4 10波林,pH调至5. 5 6. 5,在100 125°C温度下灭菌15 30分钟。
3.根据权利要求1所述的方法,其中,所述二级种子培养基是按以下方法制成的 玉米粉15 20重量份、麸皮3 8重量份、营养盐1 2重量份加水70 81重量份,混合均勻,PH调至3. 6 4. 8制成。
4.根据权利要求1所述的方法,其中,所述饲料发酵底物是按以下方法制成的 玉米粉50 70重量份、棉粕8 12重量份、豆粕8 12重量份、油菜粕4 8重量份、麸皮5 10重量份、营养盐1 2重量份、硒酸盐或亚硒酸盐0. 5 1重量份混合均勻, 制成饲料发酵底物。
5.根据权利要求3或4所述的方法,其中,所述营养盐是由磷酸二氢钾、硫酸铵、葡萄糖 按照2 4 8 12 1 3的重量比混合均勻制成。
6.根据权利要求1所述的方法,其中,所述经二级增菌培养的菌液与饲料发酵底物和 水混合步骤中,所述的水的PH值为5. 0 7. 0,所述饲料发酵底物的粒度为3 8mm,混合 完毕后将混合物堆成高为10 40cm的梯形堆,在30 45°C条件下发酵36 78小时。
7.根据权利要求1所述的方法,其中,所述烘干步骤中,控制烘干温度不高于60°C;所 述烘干后的物料的粉碎粒度为至少75%通过80目筛、至少95%通过40目筛、100%通过20 目筛。
8.根据权利要求1所述的方法,其中,所述酵母为啤酒酵母(Saccharemyces cerevisiae)CGMCC AS2. 2。
9.按照权利要求1 8任一项所述方法制备得到的饲料用硒酵母。
10.根据权利要求9所述的饲料用硒酵母,该饲料用硒酵母中有机硒含量600 1000 微克/g,酵母活菌数18亿/g以上,粗蛋白含量32%以上。
全文摘要
本发明是关于一种饲料用硒酵母及其制备方法,所述的饲料用硒酵母的制备方法是将啤酒酵母经过二级液态培养后,与饲料发酵底物和水按照1~2∶10~20∶5~10的重量比混匀,在30~45℃条件下发酵36~78小时,再将发酵结束后的物料烘干、粉碎,即得本发明的饲料用硒酵母成品。本发明的方法简便,易于规?;?。利用本发明的方法制备得到的硒酵母,其中有机硒含量高达500~1000mg/kg,同时本发明产品中含酵母活菌数可高达20亿/g,粗蛋白含量高达35%。该硒酵母产品安全无毒,投资少、见效快、效益高。
文档编号A23K1/16GK102113624SQ20091021717
公开日2011年7月6日 申请日期2009年12月31日 优先权日2009年12月31日
发明者孙晓智, 宋丽华, 岳丽莎, 岳彦, 王?;? 耿跃, 韩吉雨 申请人:内蒙古伊利实业集团股份有限公司
继续阅读
- 暂无推荐
